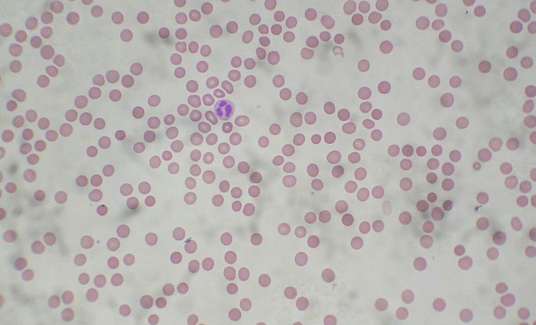

顯微鏡觀察血液(人血涂片的制作)
血涂片的顯微檢查是血液細(xì)胞學(xué)檢查的基本方法,臨床上應(yīng)用極為廣泛,制備厚薄適宜,分布均勻,染色良好的血涂片是血液學(xué)檢查的重要基本技術(shù)之一。
涂片法制片是生物顯微制片的基本方法之一。

取血步驟:
可分5個(gè)步驟進(jìn)行
消毒→取血→推片→染色→觀察
消毒與取血
消毒
先按摩取血部位,使血流通暢;再用酒精消毒采血針和取血部位(如指尖)。
待酒精干后,刺破皮膚,使血自然流出,勿擠。取干凈載片,讓血滴在離載片一端中4~5毫米處,注意手指持握載片的邊緣,勿觸及其表面。不能使載片接觸取血部位的皮膚。
推片
取一塊邊緣光滑的載片做推片。將其一端置于血滴前方,向后移動(dòng)到接觸血滴,使血液均勻分散在推片與載片的接觸處。然后使推片與載片呈30°~40°角,向另一端平穩(wěn)地推出,如右圖所示。涂片推好后,迅速在空氣中搖,使之自然干燥。
染色
用特種玻璃鉛筆在血膜兩側(cè)畫兩條線,防止染液外溢。再將瑞氏染液(伊紅-亞甲基藍(lán))滴在血膜上,至染液淹沒全部血膜,染半分鐘。加等量蒸餾水(或緩沖液)與染液混合再染5分鐘。最后用蒸餾水把染液沖掉,用吸水紙吸干,自然干燥后,即可觀察。
觀察
紅細(xì)胞
淡紅色,無(wú)核的圓形細(xì)胞,因紅細(xì)胞為雙凹形,故邊緣部分染色較深,中心較淺,直徑7-8微米。
顆粒白細(xì)胞
嗜中性顆粒白細(xì)胞:體積略大于紅細(xì)胞,細(xì)胞核被染成紫色分葉狀,可分1-5葉。直徑10-12微米。
嗜酸性顆粒白細(xì)胞:略大于嗜中性白細(xì)胞,細(xì)胞核染成紫色,通常為2葉,胞質(zhì)充滿嗜酸性大圓顆粒,被染成鮮紅色。直徑10-15微米。
嗜堿性顆粒白細(xì)胞:體積略小于嗜酸性白細(xì)胞,細(xì)胞質(zhì)中有大小不等被染成紫色的顆粒,顆粒數(shù)目較嗜酸性白細(xì)胞的顆粒少,核1-2葉,染成淡藍(lán)色。直徑10-11微米。
無(wú)顆粒白細(xì)胞
淋巴細(xì)胞:可觀察到中、小型兩種。小淋巴細(xì)胞與紅細(xì)胞大小相似,圓形,核致密,染成深紫色。周圍僅一薄層嗜堿性染成淡藍(lán)的細(xì)胞質(zhì)。中淋巴細(xì)胞較大,核圓形。直徑6-8微米。
單核細(xì)胞:體積最大,細(xì)胞圓形。胞質(zhì)染成灰藍(lán)色。核呈腎形或馬蹄形,染色略淺于淋巴細(xì)胞的核。直徑14-20微米。
血小板
血小板為不規(guī)則小體,直徑2 - 3微米。其周圍部分淺藍(lán)色,中央有細(xì)小的紫紅色顆粒,聚集成群。

注意事項(xiàng)
玻片的清洗:新玻片常有游離堿質(zhì),因此應(yīng)用清洗液或10%鹽酸浸泡24h,然后再?gòu)氐浊逑?。用過的玻片可放入適量肥皂水或合成洗滌劑的清水中煮沸20min,再用熱水將肥皂和血膜洗去,用自來(lái)水反復(fù)沖洗,必要時(shí)再置95%乙醇中浸泡1h,然后擦干或烤干備用。
使用玻片時(shí)只能手持玻片邊緣,切勿觸及玻片表面,以保持玻片清潔,干燥,中性、無(wú)油膩。
一張良好的血片,要求厚薄適宜,頭體尾分明,分布均勻,邊緣整齊, 兩側(cè)留有空隙。血片制好后最好立即固定染色,以免細(xì)胞溶解和發(fā)生退行性變。
血膜未干透,細(xì)胞尚未牢固附在玻片上,在染色過程中容易脫落, 因此血膜必需充分干燥。
生物顯微鏡
文章出自:科信儀器 轉(zhuǎn)載時(shí)必須以鏈接形式注明作者和原始出處及本聲明。 本文鏈接地址:http://m.hxcyw.net/item_63_142_0.shtml
|